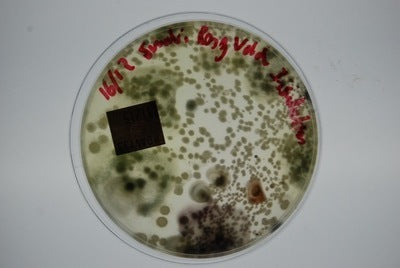

mould.net.au
6-Sample Mould Test Kit
Couldn't load pickup availability
This is suitable for testing six (6) rooms or locations/regions of interest and allows you to collect data for testing both air quality and surface contamination levels.
The kit contains:
Six (6) dishes containing potato dextrose agar which is a selective growth medium for fungi
Detailed instructions
Sterile swabs for taking surface samples
Chain of custody which ensures your lab results are suitable for analysis
Prepaid Australia Post mailer for you to return -dishes for lab analysis
Laboratory analysis including incubation and analysis to determine: the number of forming units and the Genus identification of fungi that grow where possible.
A written report including all data and a photo of the mould plates as determined after 5-7-10 days of growth (dependent on your samples)
Materials
Materials
Shipping & Returns
Shipping & Returns
Dimensions
Dimensions
Care Instructions
Care Instructions